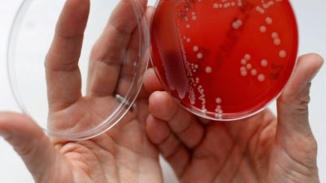
Scientists Find that Medieval Formula Can Kill Antibiotic-Resistant Bacteria MRSA Superbug

-
As Easter Approaches, Some Christians Welcome Passover alongside Jews
The Jewish people have been celebrating the tradition of Passover since Biblical times. Now some Gentiles, particularly Christians, are observing the custom of Seder before celebrating Easter.

-
California Drought Update: Gov Jerry Brown Orders Unprecedented Mandatory Water Controls
Gov. Jerry Brown, in response to the prolonged drought in California, has issued an order to cut water usage by 25 percent statewide as part of an effort to conserve the state’s dwindling water supplies.

-
Lutheran Pastor Asks Christian Business Owners to Unite against ‘Radical Gay Lobby’ Attacks
A Lutheran pastor has issued a call to support Christian business owners, arguing that religious freedom is currently under attack in the United States.

-
NBC’s ‘A.D. The Bible Continues’ Receives High Ratings from Faith Driven Consumer For Biblical accuracy
The Christian consumer group Faith Driven Consumer has reviewed “A.D. The Bible Continues,” which begins airing on NBC on Easter Sunday. The organization has given the Bible-based series 4.5 out of 5 stars.

-
Scientists Find that Medieval Formula Can Kill Antibiotic-Resistant Bacteria MRSA Superbug
Scientists and doctors have been trying to find antibiotics that would kill the dreaded drug-resistant bacteria known as MRSA. Now a formula dating back to the Middle Ages can kill the modern-day superbug.
-
Nick Vujicic's Documentary 'No Limbs, No Limits' Set for September Release
Global evangelist and motivational speaker Nick Vujicic's first biographical documentary, No Limbs, No Limits: The Nick V Story, is slated for release on September 25 this year.

-
Over 8,000 Gather in Kuala Lumpur as Malaysia's Fire Conference Ignites Wave of Spiritual Revival
A powerful spiritual revival is sweeping through Malaysia, drawing more than 8,000 attendees to the 2026 Kuala Lumpur Fire Conference (2026吉隆坡烈火特會) held from March 23 to 25.

-
Finnish Parliamentarian Found Guilty of Hate Speech Over Booklet Labeling Homosexuality a 'Disorder'
Finnish Member of Parliament and practicing physician Päivi Räsänen was convicted on March 26 of incitement against an ethnic group, following a split 3–2 court decision.

-
Bible Society Retracts ‘The Quiet Revival’ Report After YouGov Admits Data Error
Research and data analytics firm YouGov issued a statement on March 26 admitting to flaws in a 2024 study it conducted for the Bible Society. The data had been cited in the Bible Society’s widely circulated report The Quiet Revival, which claimed rising church attendance among young people signaled a “quiet revival” underway in England and Wales.

-
World Sleep Day: Unpacking Sleep Dilemmas in an Anxious Age Through 'And So To Bed'
Adrian Reynolds suggests that the Bible's understanding of sleep differs significantly from modern societal views. In his 2014 book, And So To Bed, Reynolds explores biblical perspectives on sleep, offering a different path for contemporary thought.



